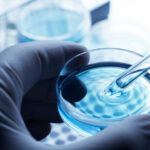

Il 22 novembre le classi III e IV I dell’indirizzo Anglo-cinese del liceo "Alessandro Volta" di Caltanissetta, accompagnate dalle professoresse Bufalino e Cumbo, hanno assistito presso il Teatro Stabile di Catania, allo spettacolo “Il giocatore”, tratto dall’ omonimo romanzo di F. Dostoevskij, portato in scena dalla Fondazione Teatro di Napoli – Teatro Bellini che, con questa produzione, ha concluso una trilogia di spettacoli dedicati al tema della libertà. Nella pièce la libertà di scelta dei personaggi è fortemente condizionata dalle loro ossessioni, prima fra tutte quella per il gioco d’ azzardo, le cui intrinseche dinamiche – il caso, l’attesa, il rischio, la dipendenza – segnano le loro vite e i loro destini.
La propedeutica lettura del testo di Dostoevskij e la visione dello spettacolo hanno permesso agli studenti di riflettere sulla devianza della ludopatia e sulle dipendenze in genere, che coinvolgono un sempre maggior numero di individui, indipendentemente dall’età e dal contesto socio-culturale di appartenenza. Per molti studenti lo spettacolo è stato anche l’occasione per scoprire una forma d’arte, il teatro, a cui le giovani generazioni si accostano spesso con diffidenza e che ci si augura, invece, possa essere sempre più apprezzato come una ineludibile occasione di svago e riflessione insieme. Il successo dell’esperienza è da attribuire anche agli attori che, dopo la eccellente performance sulla scena, si sono intrattenuti in maniera spiritosa e divertente, ma non per questo meno seria, con gli studenti alle cui domande hanno risposto con grande generosità e disponibilità.
Le attività sono proseguite nel pomeriggio con la visita dei Laboratori Nazionali del Sud – INFN (https://www.lns.infn.it/it/) , le cui attività sono rivolte sia alla ricerca di base che a quella applicata. Gli studenti sono stati accolti con grande cordialità dal prof. Pagano e dalla dott.ssa Claudia Caliri, i quali, dopo aver illustrato agli studenti la struttura dell'INFN e le sue attività di ricerca, hanno accompagnato le classi a visitare la sala di irraggiamento per la proton-terapia, utilizzata soprattutto per il trattamento di tumori agli occhi e l’ apparato di rivelazione CHIMERA, in grado di investigare le collisioni nucleari.
La visita ai Laboratori, seguita dagli studenti con grande interesse e partecipazione, è stata molto importante, sia perché i ragazzi hanno potuto accostarsi alle più moderne tecnologie utilizzate per la ricerca e conoscere gli interrogativi più attuali ai quali i ricercatori cercano di trovare una risposta, sia per il suo valore orientativo all’ interno di una didattica che vuole accostare lo studio teorico degli argomenti alla scoperta di come questi possano diventare vita vissuta, dedicata al sapere e alla conoscenza.